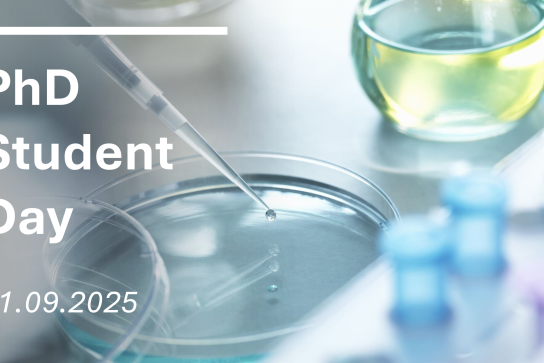
Visuel de l'évènement PhD student day UNamur-UCLouvain
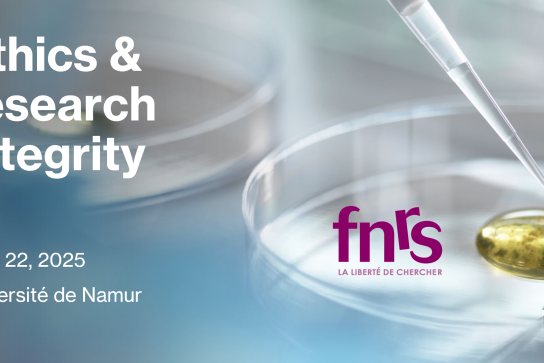
Visuel ethics and integrity et logo FNRS

Rechercher
Filtrer
Instituts
- Development Finance & Public Policies 8
- Espace philosophique de Namur 30
- Institut de Recherches en Didactiques et Education de l'UNamur 7
- Institute of Life, Earth and Environment 21
- Namur Digital Institute 19
- Namur Institute for Complex Systems 4
- Namur Institute of Language, Text and Transmediality 11
- Namur Institute of Structured Matter 16
- (-) Namur Research Institute for Life Sciences 20
- Patrimoines, transmissions, héritages 26
- Transitions 8